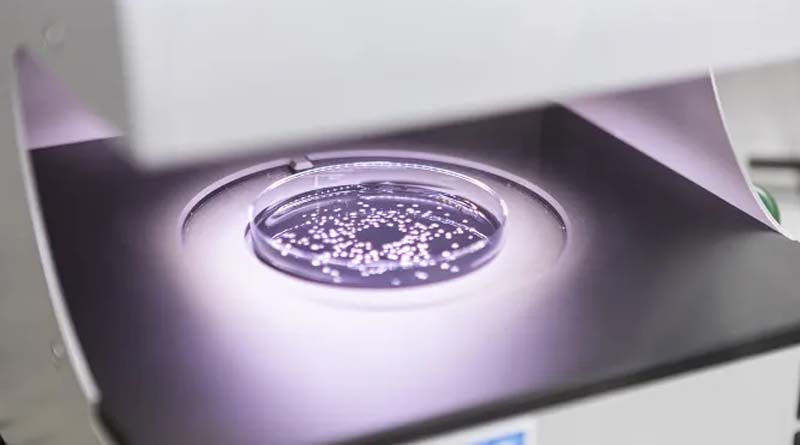
Syngenta and Amoéba SA Sign MoU to Develop and Commercialize New Biocontrol Solutions for EU and UK

Syngenta and Amoéba SA Sign MoU to Develop and Commercialize New Biocontrol Solutions for EU and UK
19 November 2025, UK: Syngenta Crop Protection and French greentech company Amoéba SA have signed a Memorandum of Understanding to jointly develop
Read More